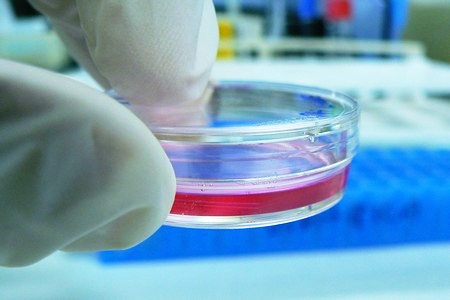
Пробирка

Шизофрения – серьезное психическое расстройство, нарушающее способность человека воспринимать реальный мир, изменяющее его поведение. Чаще всего болезнь впервые проявляется у подростков в период полового созревания. Шизофрения относится к психозам. Эта группа психических заболеваний характеризуется появлением бредов, галлюцинаций.
У шизофреника присутствует ощущение, что все вокруг него имеет особое значение, является неестественным, «подстроенным», он всегда «должен быть осторожным». Больной убежден, что окружающие его вещи только кажутся обычными, но на самом деле они кем-то или чем-то контролируются, имеют свою скрытую цель. Первое условие для определения диагноза – сохранение симптомов в течение как минимум 6 месяцев. Более сложная вещь – лечение такого сложного заболевания, как шизофрения. Лечится или нет расстройство – это вопрос неоднозначный. Сообщается, что у 1/3 пациентов полностью исчезают симптомы (при лечении на начальном этапе), у 1/3 наблюдается чередование периодов проявлений и утихания болезни, и у 1/3 симптомы присутствуют постоянно. Но означает ли устранение признаков полное исцеление или шизофрения – на всю жизнь?
Излечивается ли шизофрения?
Шизофрения относится к числу неизлечимых болезней, но правильная терапия дает пациенту возможность жить качественной жизнью, продуктивной и ценной для других. Ограничение человека должно быть минимальным. Госпитализация необходима в случае, если больной не несет ответственности за свои действия.
Врачи отмечают, что шизофрения является сложным психическим расстройством, которое на данный момент не поддается полному излечению. Тем не менее, современные методы лечения позволяют значительно улучшить качество жизни пациентов. Специалисты подчеркивают важность комплексного подхода, включающего медикаментозную терапию, психотерапию и социальную поддержку. Многие пациенты могут достичь стабильной ремиссии и вести полноценную жизнь, если они соблюдают рекомендации врачей и активно участвуют в процессе лечения. Однако важно помнить, что каждый случай индивидуален, и успех терапии зависит от множества факторов, включая своевременную диагностику и поддержку со стороны близких.

Факторы, важные для лечения
У каждого человека шизофрения лечится индивидуально, но всегда используется комплексный подход, предполагающий прием лекарств, помощь психолога. В некоторых случаях приемлемо применение народных методов лечения. В качестве успокоительного часто помогает молитва.
Диагностика на ранней стадии
Родители часто путают шизофренические признаки ребенка с проявлениями пубертатного периода, но немедленное терапевтическое вмешательство имеет решающее значение для дальнейшего развития. Улавливание симптомов детской шизофрении очень сложно, т.к. до определенного возраста ребенок может развиваться вполне нормально. Важно обратить внимание на появлении внезапного существенного изменения в поведении или общем состоянии чада, например:
- отказ от еды и твердой пищи;
- расстройства сна;
- внезапная, необъяснимая потеря веса;
- крик при виде незнакомых людей;
- закрытость от внешнего мира;
- стереотипная деятельность, иногда с обсессивно-компульсивным расстройством;
- признаки глубокого беспокойства;
- чрезмерная педантичность.
Психиатры и психологи с помощью психоанализа, включающего ряд методов, могут точно определить заболевания. Для этого используется анализ посредством игры, художественных выражений, дополнение рассказов и т.д. Важно использование цвета в рисовании. Особенно характерно применение черного цвета.
Шизофрения — сложное психическое расстройство, и мнения о его излечимости варьируются. Многие специалисты подчеркивают, что на сегодняшний день шизофрения не считается полностью излечимой, но ее симптомы можно эффективно контролировать с помощью медикаментов и психотерапии. Некоторые пациенты сообщают о значительном улучшении качества жизни и даже о периодах ремиссии, когда симптомы становятся минимальными. Однако важно отметить, что подход к лечению индивидуален и зависит от множества факторов, включая степень тяжести заболевания и поддержку со стороны близких. Общество также играет важную роль: стигматизация и недостаток информации о шизофрении могут затруднять доступ к необходимой помощи. В целом, многие эксперты согласны, что с правильным лечением и поддержкой люди с шизофренией могут вести полноценную жизнь.

Генетический эффект
В развитии и течении болезни наиболее важную роль играет генетическая предрасположенность. Шизофрения вызывается множественными генами. Эти гены не являются исключительными, они присутствуют в здоровой популяции, но баланс нарушает их сочетание. А появление отдельных генов у каждого человека определяет риск заболевания. Шизофрения – это сочетание эффектов нескольких генов. Каждый из них в отдельности не сможет вызвать болезнь.
Генетика предопределяет также ответ на лечение. Есть т.н. «нерезиденты» в отношении терапии лечения. Это люди, у которых лекарство (или группа лекарств) не имеет никакого эффекта. Сегодня проводятся интенсивные исследования в отношении наследственных диспозиций. Их цель заключается в возможности предварительного определения, какое лекарство лучше всего подавит симптомы, что сыграет важную роль в излечении шизофрении.
Другие факторы, которые следует учитывать при лечении:
- шизофрения наиболее заметно (и чаще всего) проявляется во время полового созревания;
- успех лечения зависит от приема соответствующих лекарств;
- во время лечения рекомендуется много плавать;
- целесообразно найти подходящую работу, где пациент постепенно будет становиться более уверенным в себе, укреплять свое эго.
Как лечить шизофрению?
Чем раньше, тем лучше. Хотя ответить положительно на вопрос, излечима ли шизофрения на начальной стадии, нельзя, своевременно лечимое заболевание хорошо поддается терапии.
При сохранении симптомов, несмотря на лечение, больному присваивается инвалидность.
При острой фазе заболевания иногда необходима госпитализация, корректировка лечения в стационаре. В терапии шизофрении применяются специализированные антипсихотические препараты. Назначение правильного средства осуществляется врачом, психиатром. Первый антипсихотический препарат был синтезирован в 1950 году, с тех пор было разработано несколько новых лекарств, имеющих меньше побочных эффектов. После лечения острого состояния антипсихотиками важно, чтобы человек понимал и принимал свою болезнь, осознавал необходимость приема лекарств (время, сколько лечится шизофрения, индивидуально; иногда медикаментозная терапия продолжается в течение нескольких лет, иногда может длиться на протяжении всей жизнь). Больного следует научить распознавать симптомы недуга, это предотвратит рецидивы в будущем.
Современные методы лечения
Заболевание обычно развивается несколькими фазами. Течение шизофрении варьируется в зависимости от ряда факторов. В соответствии с развитием и ходом болезни, корректируется и терапевтический курс.
Лечение острых симптомов
Средства 1-й линии в терапии острых состояний – это препараты нового поколения, содержащие рисперидон или оланзапин. Старые (классические) типы антипсихотиков применяются у пациентов, представляющих опасность, ввиду более выразительного успокаивающего действия. Значительное улучшение состояния примерно у 50% пациентов наступает не ранее, чем после месячной терапии.
Лечение хронических заболеваний
Лечение вялотекущей формы болезни также включает прием новых типов антипсихотиков. Пациенты, ненадежно принимающие лекарственные средства, иногда нуждаются в запасной (т.н. депо) форме препарата. Для продолжительной терапии врач обычно выбирает средство, эффективное при первом эпизоде шизофрении.
Лечение резистентного заболевания
В терапии шизофрении, плохо реагирующей на различные лекарственные средства, используются препараты, содержащие клозапин. В этом случае нужна терпеливость, поскольку скорость устранения симптомов более низка – улучшение может наступить через несколько месяцев, но при отсутствии эффективности других лекарств действие клозапина обеспечит значительное облегчение пациенту и его окружению.
Психотерапия
Психотерапевтический уход для пациента с шизофренией важен для его дальнейшей жизни. Он включает в себя:
- психологическое образование (объяснение основных фактов о болезни);
- профессиональную терапию;
- обучение социальным навыкам (как общаться при поиске работы, делать покупки, найти друзей);
- когнитивно-поведенческую терапию.
Важно вовлечение членов семьи. Состояние родственника – это значительный стресс для них. Как для родственников, так и для самих пациентов очень важно то, как семья отнесется к проблеме, как будет справляться с ней.
Лекарства
Выбор препарата – важный момент. За назначением лекарственного средства следует обращаться к врачу; абсолютное большинство лекарств от шизофрении доступно по рецепту, потому что речь идет о сильных психотропных препаратах.
Выбрать правильные лекарства с первого раза не всегда возможно, поэтому пациент должен находиться под постоянным медицинским наблюдением.
Лекарства лечат, но не излечивают
Антипсихотические препараты, используемые для лечения шизофрении, влияют на мыслительные процессы, снимают галлюцинации, ослабляют или меняют отношение к ним, успокаивают моторные расстройства, подавляют депрессивные, маниакальные проявления. Но ответ на вопрос, излечима ли шизофрения у женщин и мужчин при медикаментозной терапии, отрицательный – лекарства заболевание лечат, но не излечивают.
Интересный эффект на некоторые симптомы шизофрении, особенно галлюцинации, показала магнитная стимуляция — метод, основанный на применении импульсного магнитного поля, создаваемого катушкой, приложенной к поверхности головы. Этот метод непосредственно стимулирует кору на расстоянии примерно 2-3 см от катушки.
Согласно специалистам, использование определенной частоты может принести пользу хроническим пациентам с шизофренией со слуховыми галлюцинациями, у которых консервативное лечение неэффективно.
Как будет лечиться шизофрения в будущем?
Не следует бояться парадоксов, важно попытаться их понять. Нильс Бор сказал: «Нет парадокса – нет прогресса». Эти слова хорошо описывают проводящиеся исследования в отношении терапевтических методов при шизофрении.
Использование недопаминовых рецепторов
На протяжении десятилетий специалисты занимаются разработкой антипсихотиков, не работающих с парадигмой рецептора D2. Согласно ожиданиям, они будут более избирательными и безопасными. По словам исследователя Джеффри Конна из США, это могут быть вещества, действующие на мускариновые рецепторы (связываемые с нейротрансмиттером ацетилхолином в головном мозге). Экспериментально показано, что ксаномелин, влияющий на мускариновые рецепторы M1 и M4, обладает антипсихотическим эффектом, но также более выразительными побочными эффектами. На поздних стадиях клинического тестирования именно из-за наличия побочных эффектов «прогорает» ряд перспективных препаратов.
Джеффри Конн видит решение не в лекарствах, действующих на рецепторы напрямую, а только в их модуляции. Например, BQCA – фармакологическое вещество, позитивно модулирующее рецепторы M1, – положительно влияет на когнитивную функцию. Его можно использовать, особенно, для облегчения когнитивных симптомов шизофрении.
Видеоигра для лечения шизофрении
Помощь в лечении шизофрении может оказать программное обеспечение, поразительно напоминающее компьютерную игру. Специальное ПО, призванное стимулировать мозг, разработала профессор София Виноградова из Университета Сан-Франциско, США. Цель «видеоигры» – стимулировать определенные процессы для формирования новых клеток, способных взять на себя роль старых, больше не функционирующих.
Мозг в миске
При изучении шизофрении ученые все чаще работают с «искусственно созданным мозгом». Не ожидайте sci-fi, исследования мозга проводятся в лабораторных условиях с использованием стволовых клеток, выращенных в чашках Петри.
В 2012 году ученые из Института биологических наук Солка в Сан-Диего исследовали клетки пациентов с шизофренией, аутизмом и другими заболеваниями. Из их первоначально кожных клеток исследователи производили индуцированные плюрипотентные стволовые клетки (т.е. недифференцированные). Из них неврологи впоследствии формировали нейроны. В лабораторных условиях можно было подробно видеть, как они растут, как на них воздействуют новые лекарства.
Результат может быть близок
Первоначальное исследование с использованием этого метода показало, что нейроны шизофреника выглядят так же, как нейроны здоровых людей, но имеют разные синапсы (комбинация 2-х нейронов). Неожиданное открытие показало, что психиатрические препараты вызывают физические изменения в нейронах.
На каком этапе находится исследование? Ученые позволили нейронам создать синапсы в целях изучения их взаимоотношений (например, как взаимодействует дофамин или кортикальные нейроны с черным веществом).
«Понимая развитие нейронов, можно найти ключ к лечению психических расстройств», – заключает Фред Гейдж, соавтор исследования.
На сегодняшний день шизофрения неизлечима, но речь идет об относительно хорошо управляемой хронической болезни. Ключ к успеху – это индивидуальный подход к лечению, коллективная работа экспертов. Кроме того, сейчас проводятся исследования, направленные на выявление возможности полного излечения заболевания. Ученые с каждым открытием становятся ближе к разгадке природы расстройства, что, по их мнению, обеспечит определение гарантированного терапевтического метода.

Вопрос-ответ
Можно ли вообще вылечить шизофрению?
Полностью вылечить шизофрению невозможно. Главная задача врача — добиться состояния стойкой ремиссии, чтобы негативные признаки проявились как можно позже. С этой цель психотерапевт купирует обострения в условиях стационара. По возвращении шизофреника из больницы с ним должны много времени проводить родственники.
Чем сейчас лечат шизофрению?
В основном шизофрения лечится с помощью нейролептиков. Они, в свою очередь, разделяются на 2 группы: атипичные антипсихотики, конвенциональные нейролептики
Сколько лет живут с диагнозом шизофрения?
По описанным причинам продолжительность жизни людей, страдающих шизофренией, зачастую на 10–20 лет меньше, чем у людей без такого диагноза.
Можно ли убрать диагноз шизофрения?
Процесс снятия диагноза шизофрения требует времени и профессионального подхода, но при правильной организации и наличии необходимых доказательств возможно добиться пересмотра диагноза.
Советы
СОВЕТ №1
Обратитесь к специалисту. Если вы или ваши близкие испытываете симптомы, связанные с шизофренией, важно обратиться к психиатру или психотерапевту для получения профессиональной оценки и рекомендаций.
СОВЕТ №2
Изучите информацию о заболевании. Понимание шизофрении, ее симптомов и методов лечения поможет вам лучше справляться с ситуацией и поддерживать близких, страдающих от этого расстройства.
СОВЕТ №3
Поддерживайте здоровый образ жизни. Регулярные физические упражнения, сбалансированное питание и достаточный сон могут положительно сказаться на общем состоянии здоровья и помочь в управлении симптомами.
СОВЕТ №4
Не стесняйтесь обращаться за поддержкой. Общение с друзьями, семьей или группами поддержки может помочь вам справиться с эмоциональными трудностями и снизить уровень стресса, связанного с заболеванием.